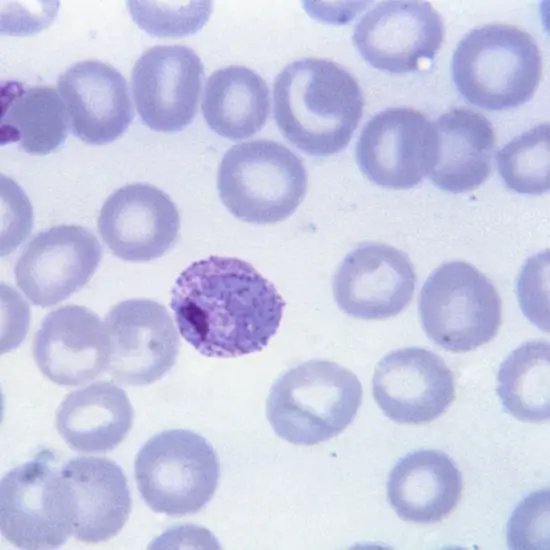
Malaria Antigen (Vivax and Falciparum)

Book Malaria Antigen (Vivax And Falciparum) Appointment Online Near me at the best price in Delhi/NCR from Ganesh Diagnostic. NABL & NABH Accredited Diagnostic centre and Pathology lab in Delhi offering a wide range of Radiology & Pathology tests. Get Free Ambulance & Free Home Sample collection. 24X7 Hour Open. Call Now at 011-47-444-444 to Book your Malaria Antigen (Vivax And Falciparum) at 50% Discount.
The malarial falciparum and viva antigen examinations analyze malaria antigens in the blood specimen. Malaria is a contagious infection that is communicated by the means of the bite of a contaminated mosquito. It is induced by the disease of a species of the Plasmodium parasite. P. falciparum ailments are correlated with cerebral malaria and drug antagonism whereas P. vivax infection is correlated with an elevated pace of infectivity and retrogression.
Your physician may suggest this examination if you suffer from indications such as fever, headache, trembling chills, and puking.
No particular practice is required before this examination. Notify your physician if you possess a record of malaria. Also, allow him/her to understand if you are accepting any prescribed, non-prescribed, or illegal drug, vitamins, or supplements.
Your physician determines you have malaria, they may request this examination to recognize which of the parasites (falciparum or viva) has induced the infection so that applicable therapy can be begun directly.
To grab the blood specimen, a tourniquet (adjustable) band is positioned tightly on the upper arm. The individual is appealed to create a fist. This assists in the buildup of blood packing the veins and it comes to be manageable to compile the blood. The skin is tidied up before putting the syringe in the vein to stave off bacteria from penetrating. The syringe is then ejected into the vein in the arm and the blood specimen is compiled in the vacutainer.
The following are the outcomes of this examination:
>> Normal results:
Normal outcomes are imprinted as negative. It implies that you do not possess any of the malaria antigens in your body and therefore do not have the disorder.
>> Abnormal results:
Abnormal outcomes are put down as positive. They imply that you retain a malaria antigen in your body and require medicine for the same thing. The examination will further notify you which malaria parasite has contaminated you (Vivax or falciparum).
| Test Type | Malaria Antigen (Vivax And Falciparum) |
| Includes | Malaria Antigen (Vivax ANd Falciparum) Test (Physician) |
| Preparation | |
| Reporting | Within 24 hours* |
| Test Price |
₹ 425
|

Early check ups are always better than delayed ones. Safety, precaution & care is depicted from the several health checkups. Here, we present simple & comprehensive health packages for any kind of testing to ensure the early prescribed treatment to safeguard your health.